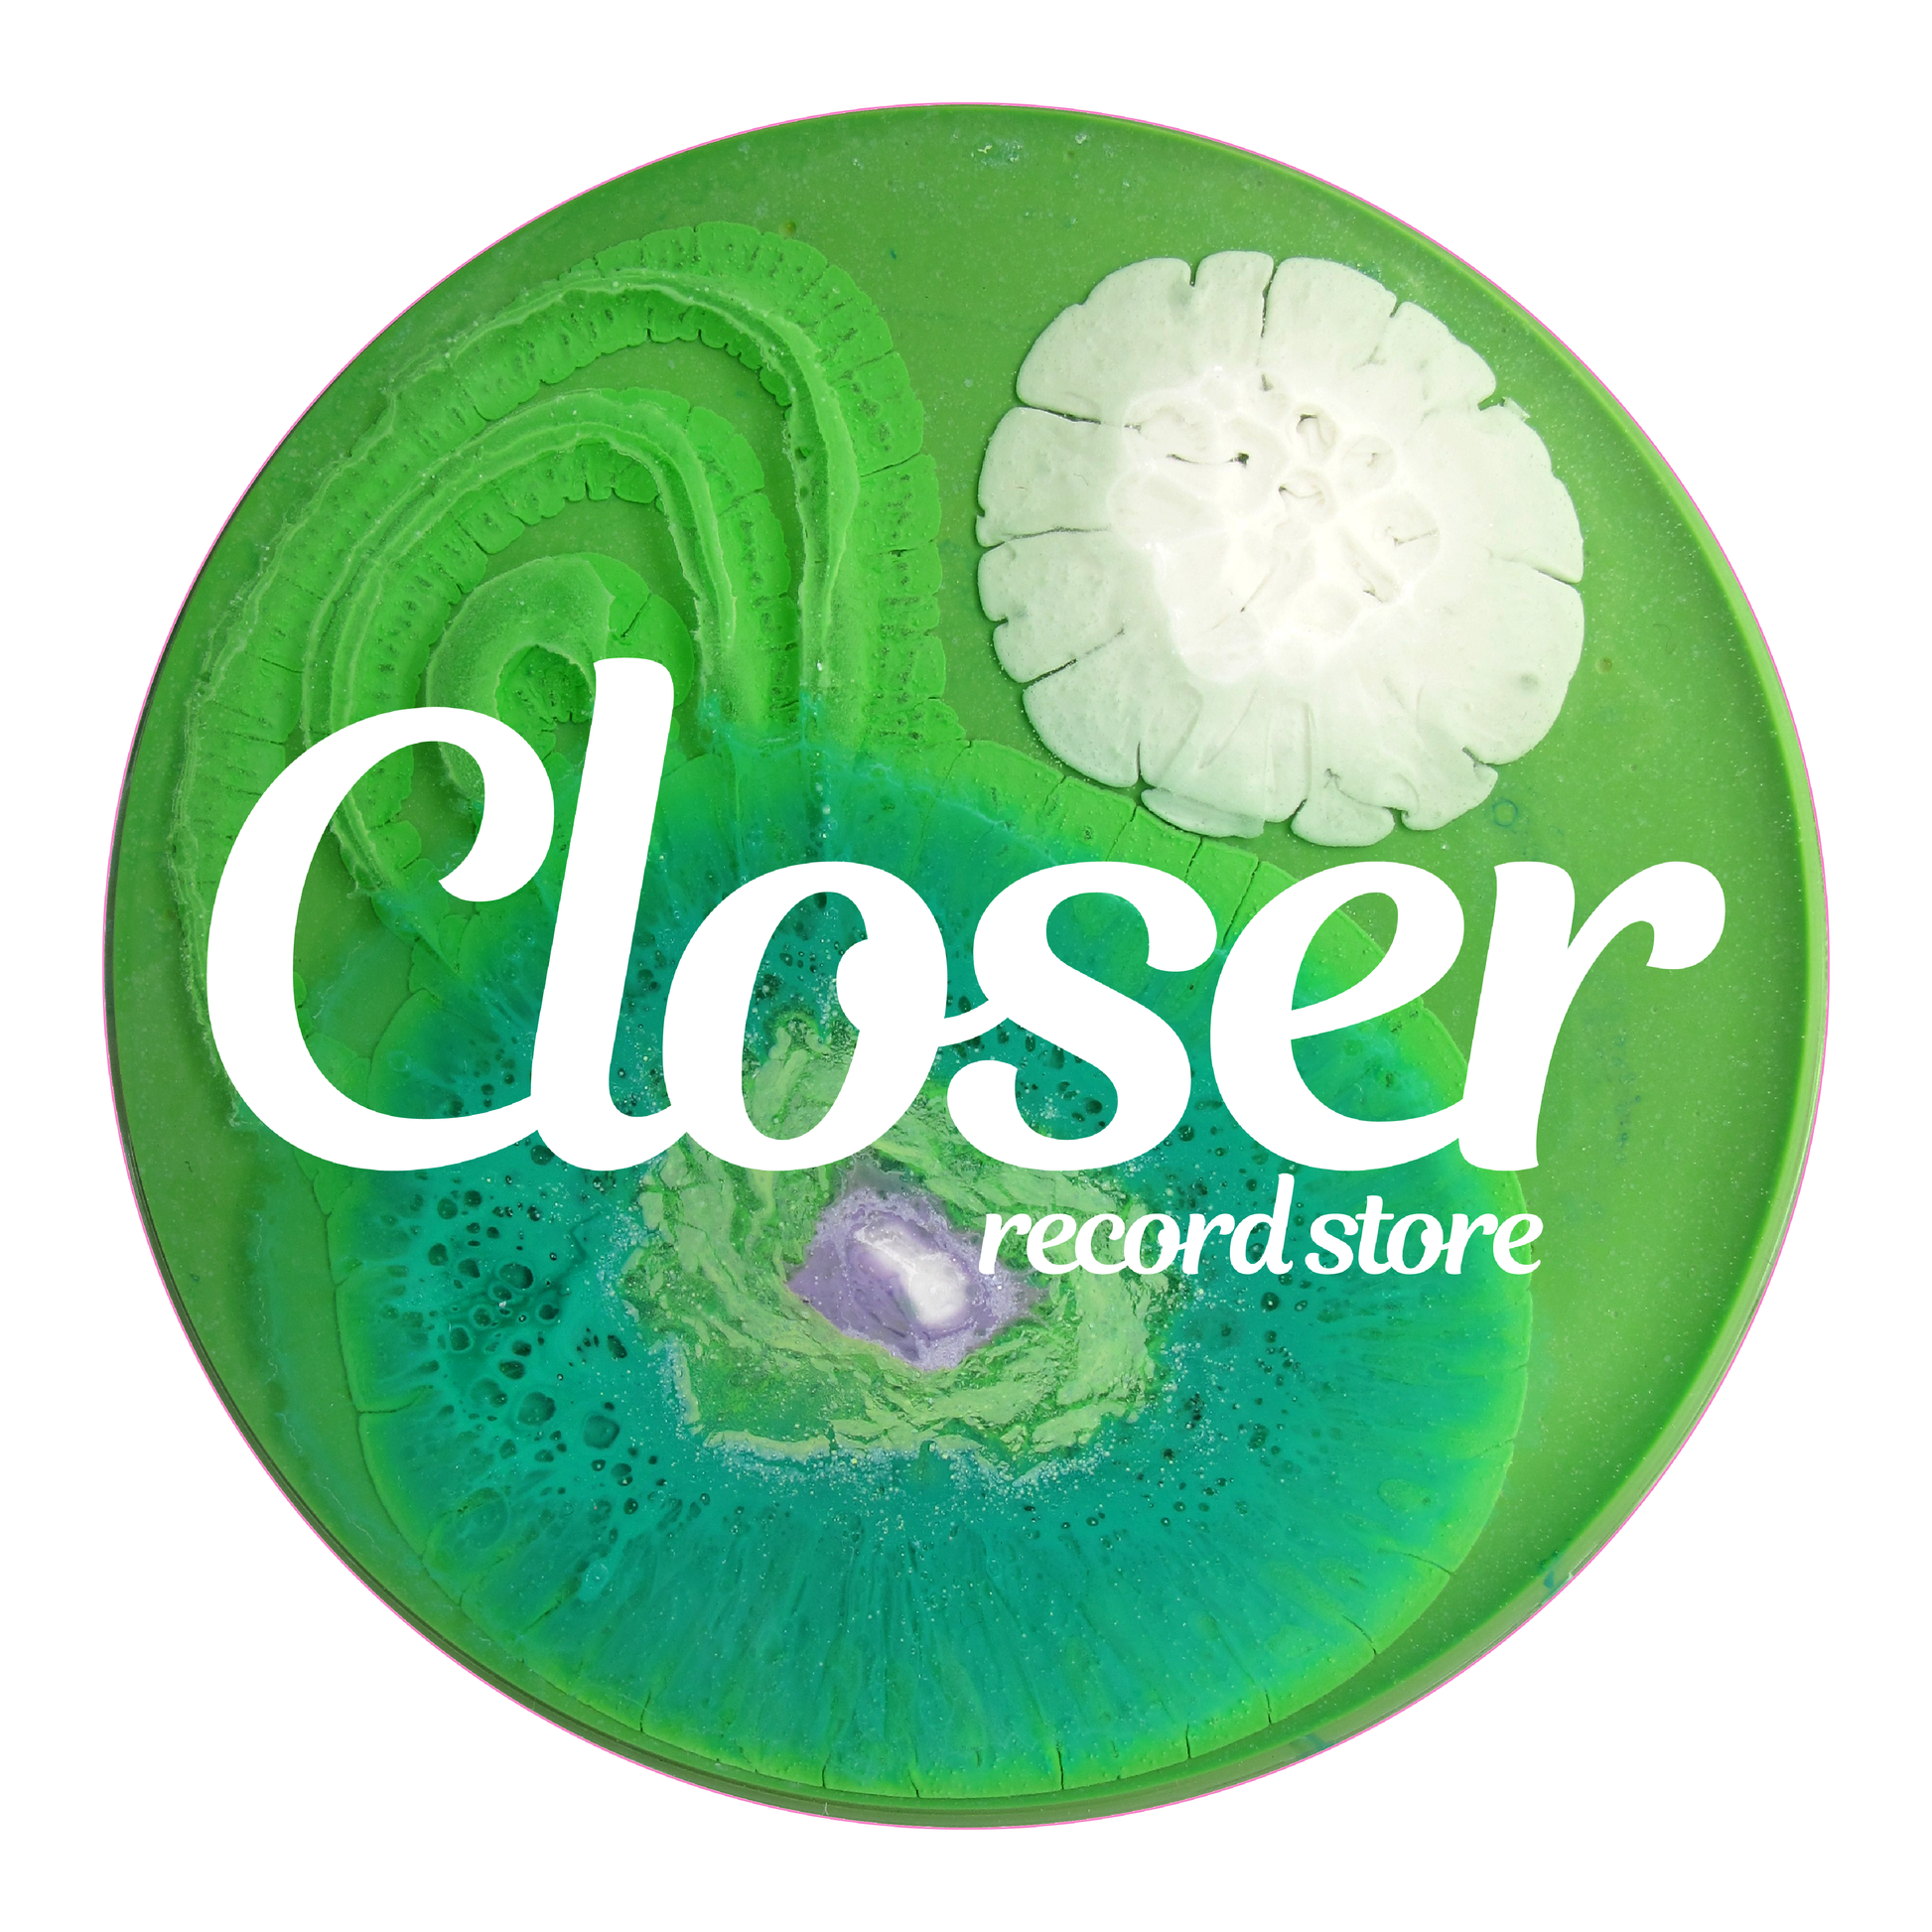

New Arrivals
-
Yanamaste - Dance EP
Regular price $35.00 AUDRegular priceUnit price / per -
Insolate - Full Disclosure LP
Regular price $55.00 AUDRegular priceUnit price / per -
Yanamaste - Evil
Regular price $38.00 AUDRegular priceUnit price / per -
Glaskin - Inertia of Motion
Regular price $38.00 AUDRegular priceUnit price / per -
JKS - Wild Nights EP
Regular price $34.00 AUDRegular priceUnit price / per -
Red Rooms - Artefacts EP
Regular price $22.00 AUDRegular priceUnit price / per -
Unknown Code - UāBahn EP
Regular price $22.00 AUDRegular priceUnit price / per -
Enter The Void - PR303.101
Regular price $22.00 AUDRegular priceUnit price / per
Pre-Order
-
Big City Bill & Neil E - Fantastic Thoughts EP
Regular price $30.00 AUDRegular priceUnit price / per
Merchandise
-
Biosonic Series Slipmats
Regular price $20.00 AUDRegular priceUnit price / per -
Closer Record Store Staff Tee (Black/White)
Regular price $60.00 AUDRegular priceUnit price / per -
Closer Record Store Staff Tee (White/Blue)
Regular price $60.00 AUDRegular priceUnit price / per -
Closer Record Store Staff Tee (White/Red)
Regular price $60.00 AUDRegular priceUnit price / per
Blog posts
View all-
From Bristol to Rose Street.
Itās been a long time coming, but weāre thrilled to offer Bristolās Untiled Distribution to our crates! Home to ec2a (Dr Dubplate) and Hardline (DJ Cosworth), theyāve been on our...
From Bristol to Rose Street.
Itās been a long time coming, but weāre thrilled to offer Bristolās Untiled Distribution to our crates! Home to ec2a (Dr Dubplate) and Hardline (DJ Cosworth), theyāve been on our...
-
A BIG DAY OUT
A night to rememberāeight hours of deep house and minimal techno on vinyl, delicious wine flowing, and Sunnyās legendary pizza keeping the crowd fueled. We took over the city alongside...
A BIG DAY OUT
A night to rememberāeight hours of deep house and minimal techno on vinyl, delicious wine flowing, and Sunnyās legendary pizza keeping the crowd fueled. We took over the city alongside...
-
A Happy Accident Ft. Pugilist
Sometimes, things just fall into place. One moment, weāre digging through Pugilistās Bandcamp, the next, weāre ordering copies from a bathtub. And just like that, he was in-store with us,...
A Happy Accident Ft. Pugilist
Sometimes, things just fall into place. One moment, weāre digging through Pugilistās Bandcamp, the next, weāre ordering copies from a bathtub. And just like that, he was in-store with us,...
Staff Picks
Explore What We Are Listening To -
-
Various - Neptune Discs Vol.10
Regular price $35.00 AUDRegular priceUnit price / per -
Eddie Richards ā- Time Travel ā Journey 2
Regular price $56.00 AUDRegular priceUnit price / per -
Echologist & Matrixxman - Offline
Regular price $22.00 AUDRegular priceUnit price / per -
Get F**ked ā- Wet Dreams
Regular price $75.00 AUDRegular priceUnit price / per
House
-
Patrice Scott / EDB & Gary Superfly - Yellow Jackets Vol.3
Regular price $35.00 AUDRegular priceUnit price / per -
Gratts & Gene Tellem - The Lifestyle EP
Regular price $32.00 AUDRegular priceUnit price / per -
DJ Junk - Disco Edits & Remixes Volume 2
Regular price $30.00 AUDRegular priceUnit price / per -
Katerina - One (Incl. Aleksi PerƤlƤ Remix) I REKIDS (REKIDS236)
Regular price $30.00 AUDRegular priceUnit price / per
Techno
-
Yanamaste - Dance EP
Regular price $35.00 AUDRegular priceUnit price / per -
Insolate - Full Disclosure LP
Regular price $55.00 AUDRegular priceUnit price / per -
Yanamaste - Evil
Regular price $38.00 AUDRegular priceUnit price / per -
Glaskin - Inertia of Motion
Regular price $38.00 AUDRegular priceUnit price / per









CLOSER
Biosonic Series Slipmats
Share